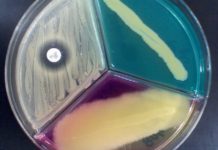
Bright Idea for Detecting Harmful Bacteria in Food Products

PhD Admissions – Biological Sciences Open @ IISER – TVM For January 2017 Session
PhD Admissions January 2017
Applications are invited from highly motivated students for admission to the Ph.D. Programme of Indian Institute of Science Education and Research...
PhD Admissions Open For Spring Semester – 2017 @ IISER, Kolkata
Doctor of Philosophy Programme (DBS)
PhD Advertisement for Spring Semester 2017 (DBS)
Applications are invited from motivated candidates having master's degree such as M.Sc/MS/ME/M.Tech/MVSc/MSc(Ag) degree or...
JRF & SRF Positions Vacant in Proteomics Department @ Aravind Medical Research Foundation (AMRF)
Aravind Medical Research Foundation (AMRF) was founded by Dr. G. Venkataswamy. The main mission of the AMRF is to eliminate needless blindness by providing...
Research Openings @ Reliance Jio | Experience in Algal Cultivation Required
At Jio, we believe in the power of technology to solve just about anything. That's why we gather some of the sharpest minds and...
Advertisement for the Posts of JRF in DST-SERB Sponsored Project @ Manipal University
DEPARTMENT OF BIOTECHNOLOGY
(CANCER AND MOLECULAR BIOLOGY DIVISION)
MANIPUR UNIVERSITY
Advertisement for the Posts of JRF in DST-SERB Sponsored Project
Applications are invited for two (2) Junior Research...
Work As Senior Scientific Assistant in Govt Sector @ GEMI | Salary : Rs...
GUJARAT ENVIRONMENT MANAGEMENT INSTITUTE (GEMI)
(An Autonomous Institute of Government of Gujarat)
Block No. 13, Third Floor, Dr. Jivraj Mehta Bhavan (Old Sachivalaya), Sector-10B,...
Lambda Therapeutic Hiring M.sc Biochemistry Candidates For the Post Of Research Associate – Bioanalytical
Lambda Therapeutic Research Limited is a leading global Clinical Research Organization (CRO) headquartered in Ahmedabad - India, with facilities and operations in Mumbai (India),...
Notification For “Tata Innovation Fellowship” | Fellowship Amount : Rs 25,000/- pm + Rs...
GOVERNMENT OF INDIA
DEPARTMENT OF BIOTECHNOLOGY
MINISTRY OF SCIENCE & TECHNOLOGY
TATA INNOVATION FELLOWSHIP: 2016-17
Applications are invited for “Tata Innovation Fellowship”, a highly competitive
scheme instituted by the...
Applications Invited For ” NACO-Research Fellowship Scheme ” | Fellowship Grant : Rs 1.5...
T-11020/21/08 NACO (R&D) Vol 2
Government of India Ministry of Health & Family Welfare
(National AIDS Control Organization)
Circular
NACO-Research Fellowship Scheme
NACO invites applications in prescribed...
Govt Job : UP State AIDS Control Society (UPSACS) Hiring For Quality Manager Post
Uttar Pradesh State AIDS Control Society (UPSACS) was formally registered in the Year 1999 as a para-statal agency. The governing board includes the Principal...
INSA ( Indian National Science Academy ) Medal For Young Scientists 2017
INDIAN NATIONAL SCIENCE ACADEMY
NEW DELHI
SCOPE
INSA Medal for Young Scientists instituted in 1974 by the Indian National Science
Academy and awarded annually are intended to honour...
Work @ Centre For DNA Fingerprinting & Diagnostics As Research Associate / JRF /...
CENTRE FOR DNA FINGERPRINTING AND DIAGNOSTICS
www.cdfd.org.in
Advt. No. CDFD/EMPC/1/Sep’ 16
CDFD, an autonomous institute of the Department of Biotechnology, Ministry of Science and Technology, invites applications...
Notification For CSIR – NISCAIR Research Intern Award
National Institute of Science Communication And Information Resource (NISCAIR) is devoted to science communication and dissemination and S&T information. Broadly the core activity of...
Scientists Discover Distant DNA Working Together to affect Disease Risk
Is this another layer of gene control?
A person's DNA sequence can provide a lot of information about how genes are turned on and off,...
Bright Idea for Detecting Harmful Bacteria in Food Products
Scientists looking for traces of E. coli O157:H7 contamination in foods soon could have a new detection method on their hands -- turning off...